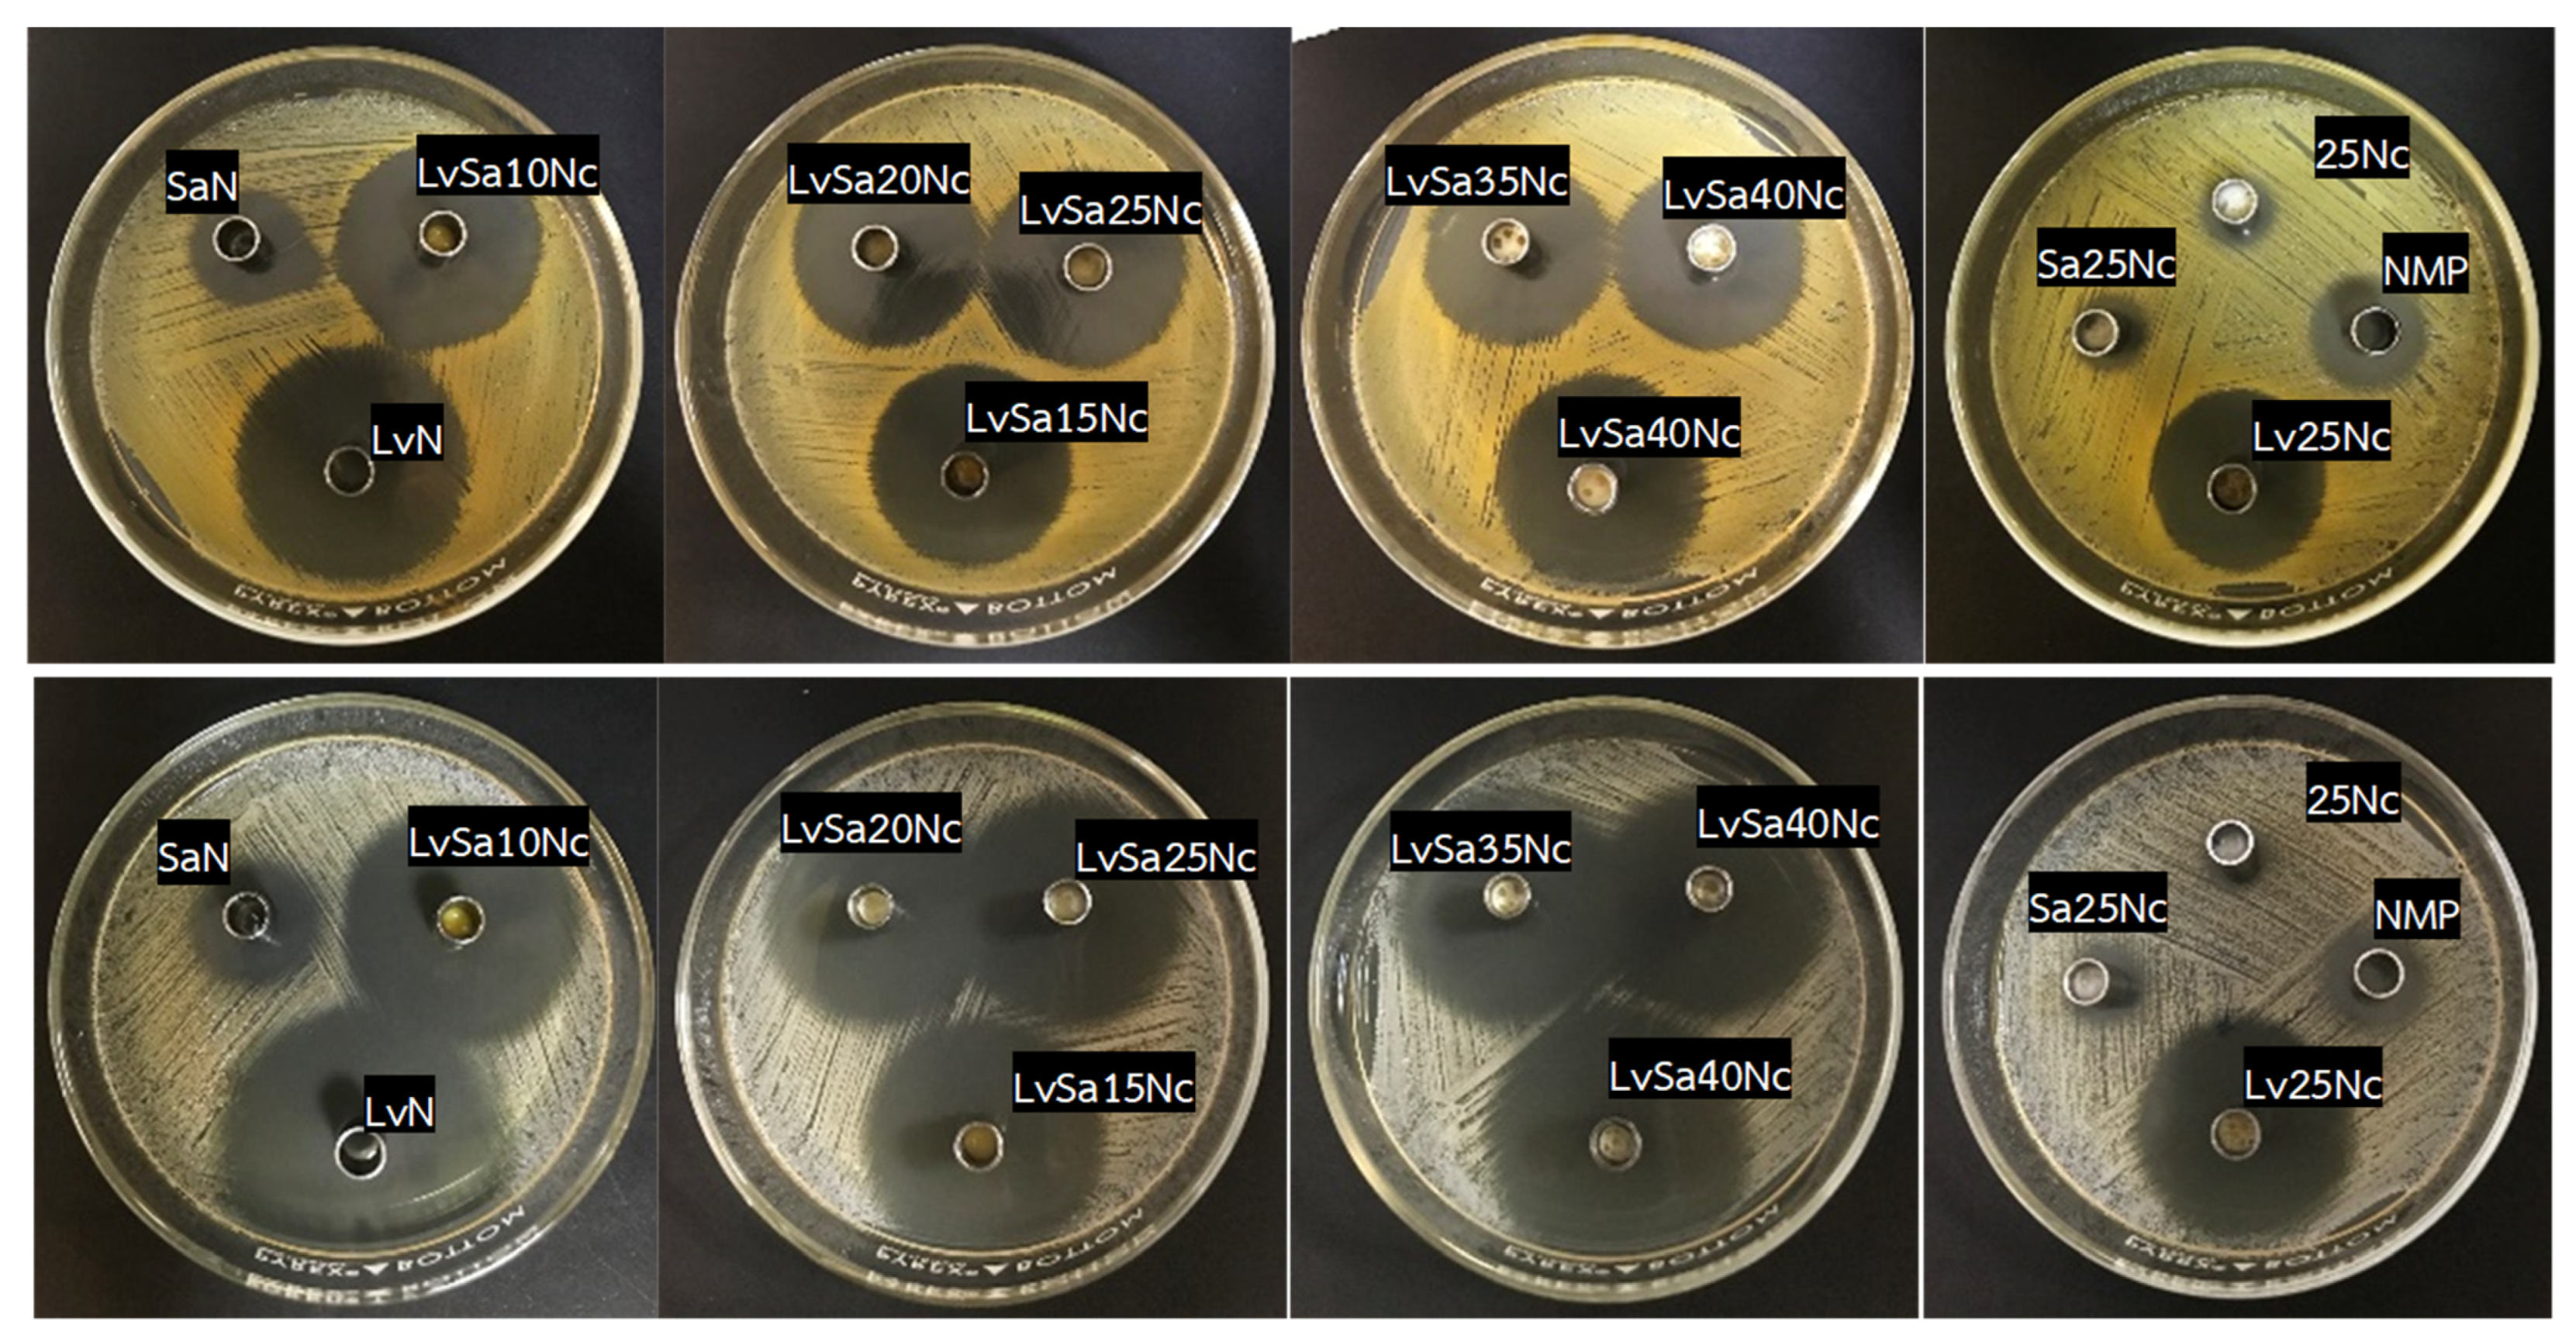
Polymers 16 00989 g012

Nitrocellulose for Prolonged Permeation of Levofloxacin HCl-Salicylic Acid In Situ Gel
Abstract
1. Introduction
2. Materials and Methods
2.1. Materials
2.2. Preparation of In Situ Gel Formulations
2.3. Evaluations
2.3.1. Physical Appearance and Measurements of Viscosity and Rheology
2.3.2. Contact Angle Determination
2.3.3. Gel Formation Study
2.3.4. Study of Mechanical Properties
2.3.5. Study of Microscopic Interfacial Behavior
2.3.6. In Vitro Permeation Study
2.3.7. In Vitro Anti-Inflammatory Study
2.3.8. Antimicrobial Activity Test
2.4. Statistical Analysis
3. Results and Discussion
3.1. Physical Appearance and Viscosity
3.2. Contact Angle
3.3. Gel Formation
3.4. Mechanical Properties
3.5. Fluorescent Tracking Matrix formation and Solvent Movement
3.6. Drug Permeation
3.7. In Vitro Anti-Inflammatory Capabilities
3.8. Antibacterial Activities
4. Conclusions
Author Contributions
Funding
Institutional Review Board Statement
Data Availability Statement
Acknowledgments
Conflicts of Interest
References
- Ghasemiyeh, P.; Mohammadi-Samani, S.; Noorizadeh, K.; Zadmehr, O.; Rasekh, S.; Mohammadi-Samani, S.; Dehghan, D. Novel topical drug delivery systems in acne management: Molecular mechanisms and role of targeted delivery systems for better therapeutic outcomes. J. Drug Deliv. Sci. Technol. 2022, 74, 103595. [Google Scholar] [CrossRef]
- Gollnick, H.; Cunliffe, W.; Berson, D.; Dreno, B.; Finlay, A.; Leyden, A.J.; Shalita, A.R.; Thiboutot, D. Management of Acne: A Report From a Global Alliance to Improve Outcomes in Acne. J. Am. Acad. Dermatol. 2003, 49, S1–S38. [Google Scholar] [CrossRef] [PubMed]
- Vyas, A.; Kumar Sonker, A.; Gidwani, B. Carrier-based drug delivery system for treatment of acne. Sci. World J. 2014, 2014, 276260. [Google Scholar] [CrossRef] [PubMed]
- Amato, M.; Santonocito, S.; Polizzi, A.; Tartaglia, G.M.; Ronsivalle, V.; Viglianisi, G.; Grippaudo, C.; Isola, G. Local Delivery and Controlled Release Drugs Systems: A New Approach for the Clinical Treatment of Periodontitis Therapy. Pharmaceutics 2023, 15, 1312. [Google Scholar] [CrossRef] [PubMed]
- Jitrangsri, K.; Lertsuphotvanit, N.; Kabthong, N.; Phaechamud, T. Metronidazole-Loaded Camphor-Based In Situ Forming Matrix for Periodontitis Treatment. AAPS PharmSciTech 2023, 24, 185. [Google Scholar] [CrossRef] [PubMed]
- Pragati, S.; Ashok, S.; Kuldeep, S. Recent advances in periodontal drug delivery systems. Int. J. Drug Deliv. 2009, 1, 1–14. [Google Scholar] [CrossRef]
- Senarat, S.; Pornsawad, P.; Lertsuphotvanit, N.; Østergaard, J.; Phaechamud, T. Numerical Mechanistic Modelling of Drug Release from Solvent-Removal Zein-Based In Situ Gel. Pharmaceutics 2023, 15, 2401. [Google Scholar] [CrossRef] [PubMed]
- Mattar, H.; Baz, Z.; Saleh, A.; Shalaby, A.H.; Azzazy, A.E.; Salah, H.; Ismail, I. Nitrocellulose: Structure, Synthesis, Characterization, and Applications. Water Energy Food Environ. 2020, 1, 1–15. [Google Scholar]
- Liu, J. Nitrate Esters Chemistry and Technology; Springer: Singapore, 2019; pp. 469–476. [Google Scholar] [CrossRef]
- Sun, S.; Feng, S.; Ji, C.; Shi, M.; He, X.; Xu, F.; Lu, T.J. Microstructural effects on permeability of Nitrocellulose membranes for biomedical applications. J. Membr. Sci. 2020, 595, 117502. [Google Scholar] [CrossRef]
- Fridley, G.E.; Holstein, C.A.; Oza, S.B.; Yager, P. The evolution of nitrocellulose as a material for bioassays. MRS Bull. 2013, 38, 326–330. [Google Scholar] [CrossRef]
- Mu, X.; Yu, H.; Zhang, C.; Chen, X.; Cheng, Z.; Bai, R.; Wu, X.; Yu, Q.; Wu, C.; Diao, Y. Nano-porous nitrocellulose liquid bandage modulates cell and cytokine response and accelerates cutaneous wound healing in a mouse model. Carbohydr. Polym. 2016, 136, 618–629. [Google Scholar] [CrossRef] [PubMed]
- Senarat, S.; Rojviriya, C.; Sarunyakasitrin, K.; Charoentreeraboon, J.; Pichayakorn, W.; Phaechamud, T. Moxifloxacin HCl-Incorporated Aqueous-Induced Nitrocellulose-Based In Situ Gel for Periodontal Pocket Delivery. Gels 2023, 9, 572. [Google Scholar] [CrossRef] [PubMed]
- Vall, M.; Ferraz, N.; Cheung, O.; Strømme, M.; Zardán Gómez de la Torre, T. Exploring the Use of Amine Modified Mesoporous Magnesium Carbonate for the Delivery of Salicylic Acid in Topical Formulations: In Vitro Cytotoxicity and Drug Release Studies. Molecules 2019, 24, 1820. [Google Scholar] [CrossRef] [PubMed]
- Woo, J.O.; Misran, M.; Lee, P.F.; Tan, L.P. Development of a controlled release of salicylic acid loaded stearic acid-oleic acid nanoparticles in cream for topical delivery. Sci. World J. 2014, 2014, 205703. [Google Scholar] [CrossRef] [PubMed]
- González, R.; Welsh, O.; Ocampo, J.; Hinojosa-Robles, R.M.; Vera-Cabrera, L.; Delaney, M.L.; Gómez, M. In vitro antimicrobial susceptibility of Propionibacterium acnes isolated from acne patients in northern Mexico. Int. J. Dermatol. 2010, 49, 1003–1007. [Google Scholar] [CrossRef] [PubMed]
- Fox, L.; Csongradi, C.; Aucamp, M.; du Plessis, J.; Gerber, M. Treatment Modalities for Acne. Molecules 2016, 21, 1063. [Google Scholar] [CrossRef] [PubMed]
- Uchida, S. Once-daily levofloxacin is effective for inflammatory acne and achieves high levels in the lesions: An open study. J. Am. Acad. Dermatol. 2012, 66 (Suppl. S1), AB17. [Google Scholar] [CrossRef]
- Kawada, A.; Aragane, Y.; Tezuka, T. Levofloxacin Is Effective for Inflammatory Acne and Achieves High Levels in the Lesions: An Open Study. Dermatology 2002, 204, 301–302. [Google Scholar] [CrossRef] [PubMed]
- Sheth, S.K.; Mundada, A.; Gokhale, N.; Mahajan, P. Comparision of oral levofloxacin and minocycline in treatment of inflammatory acne vulgaris: A randomized control trial. Indian J. Drugs Dermatol. 2018, 4, 7–12. [Google Scholar] [CrossRef]
- Davis, R.; Bryson, H.M. Levofloxacin. A review of its antibacterial activity, pharmacokinetics and therapeutic efficacy. Drugs 1994, 47, 677–700. [Google Scholar] [CrossRef]
- Stein, G.E.; Goldstein, E.J.C. Review of the in vitro activity and potential clinical efficacy of levofloxacin in the treatment of anaerobic infections. Anaerobe 2003, 9, 75–81. [Google Scholar] [CrossRef] [PubMed]
- Eldeeb, A.E.; Salah, S.; Mabrouk, M.; Amer, M.S.; Elkasabgy, N.A. Dual-drug delivery via zein in situ forming implants augmented with titanium-doped bioactive glass for bone regeneration: Preparation, in vitro characterization, and in vivo evaluation. Pharmaceutics 2022, 14, 274. [Google Scholar] [CrossRef] [PubMed]
- Jitrangsri, K.; Khaing, E.M.; Intaraphairot, T.; Phaechamud, T.; Mahadlek, J. Injectable Gamboge-Based In Situ Gel for Sustained Delivery of Imatinib Mesylate. Gels 2023, 9, 737. [Google Scholar] [CrossRef] [PubMed]
- Reynolds, R.V.; Yeung, H.; Cheng, C.F.; Cook-Bolden, F.; Desai, S.R.; Druby, K.M.; Freeman, E.E.; Keri, J.E.; Gold, L.F.S.; Tan, J.K.; et al. Guidelines of care for the management of acne vulgaris. J. Am. Acad. Dermatol. 2024, 30, 2024. [Google Scholar] [CrossRef] [PubMed]
- Lu, J.; Cong, T.; Wen, X.; Li, X.; Du, D.; He, G.; Jiang, X. Salicylic acid treats acne vulgaris by suppressing AMPK/SREBP1 pathway in sebocytes. Exp. Dermatol. 2019, 28, 786–794. [Google Scholar] [CrossRef] [PubMed]
- Senarat, S.; Tuntarawongsa, S.; Lertsuphotvanit, N.; Rojviriya, C.; Phaechamud, T.; Chantadee, T. Levofloxacin HCl-Loaded Eudragit L-Based Solvent Exchange-Induced In Situ Forming Gel Using Monopropylene Glycol as a Solvent for Periodontitis Treatment. Gels 2023, 9, 583. [Google Scholar] [CrossRef]
- Puyathorn, N.; Lertsuphotvanit, N.; Chantadee, T.; Pichayakorn, W.; Phaechamud, T. Lincomycin HCl-Loaded Borneol-Based In Situ Gel for Periodontitis Treatment. Gels 2023, 9, 495. [Google Scholar] [CrossRef] [PubMed]
- Madan, M.; Bajaj, A.; Lewis, S.; Udupa, N.; Bai, J.A. In situ forming polymeric drug delivery systems. Indian J. Pharm. Sci. 2009, 71, 242–251. [Google Scholar] [CrossRef] [PubMed]
- Himawan, C.; Starov, V.M.; Stapley, A.G. Thermodynamic and kinetic aspects of fat crystallization. Adv. Colloid Interface Sci. 2006, 122, 3–33. [Google Scholar] [CrossRef]
- Wanasathop, A.; Murawsky, M.; Li, S.K. Modification of small dissolution chamber system for long-acting periodontal drug product evaluation. Int. J. Pharm. 2022, 618, 121646. [Google Scholar] [CrossRef]
- Basak, S.; Bandyopadhyay, A. Solvent Responsive Shape Memory Polymers-Evolution, Current Status, and Future Outlook. Macromol. Chem. Phys. 2021, 222, 2100195. [Google Scholar] [CrossRef]
- Nishio, I.; Akiyoshi, W. Quasi-Elastic Light Scattering Study of Concentration Dependence of Diffusion and Internal Motion in Chain Polymers. Polym. J. 1980, 12, 145–152. [Google Scholar] [CrossRef]
- Do, M.P.; Neut, C.; Delcourt, E.; Certo, S.T.; Siepmann, J.; Siepmann, F. In situ forming implants for periodontitis treatment with improved adhesive properties. Eur. J. Pharm. Biopharm. 2014, 88, 342–350. [Google Scholar] [CrossRef]
- Phaechamud, T.; Senarat, S.; Puyathorn, N.; Praphanwittaya, P. Solvent exchange and drug release characteristics of doxycycline hyclate-loaded bleached shellac in situ-forming gel and -microparticle. Int. J. Biol. Macromol. 2019, 135, 1261–1272. [Google Scholar] [CrossRef]
- Mei, L.; Huang, X.; Xie, Y.; Chen, J.; Huang, Y.; Wang, B.; Wang, H.; Pan, X.; Wu, C. An injectable in situ gel with cubic and hexagonal nanostructures for local treatment of chronic periodontitis. Drug Deliv. 2017, 24, 1148–1158. [Google Scholar] [CrossRef] [PubMed]
- Lipson, B.K.; Yannuzzi, L.A. Complications of intravenous fluorescein injections. Int. Ophthalmol. Clin. 1989, 29, 200–205. [Google Scholar] [CrossRef] [PubMed]
- Alemán-Nava, G.S.; Cuellar-Bermudez, S.P.; Cuaresma, M.; Bosma, R.; Muylaert, K.; Ritmann, B.E.; Parra, R. How to use Nile Red, a selective fluorescent stain for microalgal neutral lipids. J. Microbiol. Methods. 2016, 128, 74–79. [Google Scholar] [CrossRef]
- Martinez, V.; Henary, M. Nile red and nile blue: Applications and syntheses of structural analogues. Chemistry 2016, 22, 13764–13782. [Google Scholar] [CrossRef]
- Mollerup, S.; Friis-Nielsen, J.; Vinner, L.; Hansen, T.A.; Richter, S.R.; Fridholm, H.; Herrera, J.A.R.; Lund, O.; Brunak, S.; Izarzugaza, J.M.G.; et al. Propionibacterium acnes: Disease-causing agent or common contaminant? Detection in diverse patient samples by next-generation sequencing. J. Clin. Microbiol. 2016, 54, 980–987. [Google Scholar] [CrossRef]
- Vasam, M.; Korutla, S.; Bohara, R.A. Acne vulgaris: A review of the pathophysiology, treatment, and recent nanotechnology based advances. Biochem. Biophys. Rep. 2023, 36, 101578. [Google Scholar] [CrossRef]
- Misra, A.; Raghuvanshi, R.S.; Ganga, S.; Diwan, M.; Talwar, G.; Singh, O. Formulation of a transdermal system for biphasic delivery of testosterone. J. Control. Release. 1996, 39, 1–7. [Google Scholar] [CrossRef]
- Cilurzo, F.; Vistoli, G.; Selmin, F.; Gennari, C.G.; Musazzi, U.M.; Franzé, S.; Lo Monte, M.; Minghetti, P. An insight into the skin penetration enhancement mechanism of N-methylpyrrolidone. Mol. Pharm. 2014, 11, 1014–1021. [Google Scholar] [CrossRef]
- Dołowy, M.; Pyka, A. Lipophilicity Study of Salicylic and Acetylsalicylic Acids Using Both Experimental and Calculations Methods. J. Liq. Chromatogr. Relat. Technol. 2014, 38, 485–491. [Google Scholar] [CrossRef]
- Czyrski, A. The spectrophotometric determination of lipophilicity and dissociation constants of ciprofloxacin and levofloxacin. Spectrochim. Acta Part A: Mol. Biomol. Spectrosc. 2022, 265, 120343. [Google Scholar] [CrossRef]
- Ji, S.; Choi, Y. Microbial and Host Factors That Affect Bacterial Invasion of the Gingiva. J. Dent. Res. 2020, 99, 1013–1020. [Google Scholar] [CrossRef]
- Mendes, L.; Azevedo, N.J.; Felino, A.; Pinto, M.G. Relationship between invasion of the periodontium by periodontal pathogens and periodontal disease: A systematic review. Virulence 2015, 6, 208–215. [Google Scholar] [CrossRef]
- Wanasathop, A.; Zhong, C.; Nimmansophon, P.; Murawsky, M.; Li, S.K. Characterization of Porcine Gingiva for Drug Absorption. J. Pharm. Sci. 2023, 112, 1032–1040. [Google Scholar] [CrossRef]
- Chaiya, P.; Senarat, S.; Phaechamud, T.; Narakornwit, W. In Vitro Anti-Inflammatory Activity Using Thermally Inhibiting Protein Denaturation of Egg Albumin and Antimicrobial Activities of Some Organic Solvents. Mater. Today Proc. 2022, 65, 2290–2295. [Google Scholar] [CrossRef]
- Sen, S.; Chakraborty, R.; Maramsa, N.; Basak, M.; Deka, S.; Dey, B.K. In vitro anti-inflammatory activity of Amaranthus caudatus L leaves. Indian J. Nat. Prod. Resour. 2015, 6, 326–329. [Google Scholar]
- Roche-Molina, M.; Hardwick, B.; Sanchez-Ramos, C.; Sanz-Rosa, D.; Gewert, D.; Cruz, F.M.; Gonzalez-Guerra, A.; Andres, V.; Palma, J.A.; Ibanez, B.; et al. The Pharmaceutical Solvent N-Methyl-2-Pyrollidone (NMP) Attenuates Inflammation through Krüppel-like Factor 2 Activation to Reduce Atherogenesis. Sci. Rep. 2020, 10, 11636. [Google Scholar] [CrossRef]
- Randjelović, P.; Veljković, S.; Stojiljković, N.; Sokolović, D.; Ilić, I.; Laketić, D.; Randjelović, D.; Randjelović, N. The Beneficial Biological Properties of Salicylic Acid. Acta Fac. Medicae Naissensis 2015, 32, 259–265. [Google Scholar] [CrossRef]
- Sostres, C.; Gargallo, C.J.; Arroyo, M.T.; Lanas, A. Adverse effects of non-steroidal anti-inflammatory drugs (NSAIDs, aspirin and coxibs) on upper gastrointestinal tract. Best Pract. Res. Clin. Gastroenterol. 2010, 24, 121–132. [Google Scholar] [CrossRef]
- Badari, M.S.; Elgendy, S.G.; Mohamed, A.S.; Hassan, A.T. Immunomodulatory Effects of Levofloxacin on Patients with Pneumonia in Assiut University Hospitals. Egypt J. Immunol. 2015, 22, 79–85. [Google Scholar]
- Valenze, G.; Veihelamann, S.; Peplies, J.; Tichy, D.; Roldan-Pareja, M.C.; Schlagenhaul, U.; Vogel, U. Microbial changes in periodontitis successfully treated by mechanical plaque removal and systemic amoxicillin and metronidazole. Int. J. Med. Microbiol. 2009, 299, 427–438. [Google Scholar] [CrossRef]
- Vitt, A.; Sofrata, A.; Slizen, V.; Sugars, R.V.; Gustafsson, A.; Gudkova, E.I.; Kazeko, L.A.; Ramberg, P.; Buhlin, K. Antimicrobial activity of polyhexamethylene guanidine phosphate in comparison to chlorhexidine using the quantitative suspension method. Ann. Clin. Microbiol. Antimicrob. 2015, 14, 36. [Google Scholar] [CrossRef]
- Amel, Y.; Bouziane, D.; Leila, M.; Ahmed, B. Microbiological study of periodontitis in the West of Algeria. World J. Med. Sci. 2010, 5, 7–12. [Google Scholar]
- Pradeep, A.R.; Singh, S.P.; Martande, S.S.; Naik, S.B.; Kalra, N.; Suke, D.K. Clinical and microbiological effects of levofloxacin in the treatment of chronic periodontitis: A randomized, placebo-controlled clinical trial. J. Investig. Clin. Dent. 2015, 6, 170–178. [Google Scholar] [CrossRef]
- Fiume, M.M.; Bergfeld, W.F.; Belsito, D.V.; Hill, R.A.; Klaassen, C.D.; Liebler, D.C.; Marks, J.J.G.; Shank, R.C.; Slaga, T.J.; Snyder, P.W.; et al. Safety Assessment of Nitrocellulose and Collodion as Used in Cosmetics. Int. J. Toxicol. 2016, 35, 50S–59S. [Google Scholar] [CrossRef]
- Phaechamud, T.; Mahadlek, J.; Charoenteeraboon, J.; Choopun, S. Characterization and antimicrobial activity of N-methyl-2-pyrrolidone-loaded ethylene oxide-propylene oxide block copolymer thermosensitive gel. Indian J. Pharm. Sci. 2013, 74, 498–504. [Google Scholar] [CrossRef]
- Jouyban, A.; Fakhree, M.A.; Shayanfar, A. Review of pharmaceutical applications of N-methyl-2-pyrrolidone. J. Pharm. Pharmaceut. Sci. 2010, 13, 524–535. [Google Scholar] [CrossRef]
- Strickley, R.G. Solubilizing excipients in oral and injectable formulations. Pharm. Res. 2004, 21, 201–230. [Google Scholar] [CrossRef] [PubMed]
- Hansen, C.M.; Just, L. Prediction of environmental stress cracking in plastics with Hansen solubility. Ind. Eng. Chem. Res. 2001, 40, 21–25. [Google Scholar] [CrossRef]
- Reza, M.S.; Quadir, M.A.; Haider, S.S. Comparative evaluation of plastic, hydrophobic and hydrophilic matrices for controlled-release drug delivery. J. Pharm. Phramacet. Sci. 2003, 6, 282–291. [Google Scholar]

| Formulation | Concentration (% w/w) | |||
|---|---|---|---|---|
| Levofloxacin HCl | Salicylic Acid | Nitrocellulose | NMP | |
| LvN | 1 | 99 | ||
| SaN | 2 | 98 | ||
| LvSa10Nc | 1 | 2 | 10 | 87 |
| LvSa15Nc | 1 | 2 | 15 | 82 |
| LvSa20Nc | 1 | 2 | 20 | 77 |
| LvSa25Nc | 1 | 2 | 25 | 72 |
| LvSa30Nc | 1 | 2 | 30 | 67 |
| LvSa35Nc | 1 | 2 | 35 | 62 |
| LvSa40Nc | 1 | 2 | 40 | 57 |
| Lv25Nc | 1 | 2 | 25 | 74 |
| Sa25Nc | 2 | 25 | 73 | |
| 25Nc | 25 | 75 | ||
| NMP | 100 | |||
| Formula | Contact Angle ± S.D. (Degree) (n = 3) | |
|---|---|---|
| Glass Slide | Agarose | |
| LvSa10Nc | 12.68 ± 2.32 b | 18.71 ± 2.82 b |
| LvSa15Nc | 12.88 ±1.12 c | 17.13 ± 2.70 c |
| LvSa20Nc | 15.15 ± 2.93 d | 22.04 ± 2.02 d |
| LvSa25Nc | 21.48 ± 2.98 e | 32.71 ± 3.32 e |
| LvSa30Nc | 30.72 ± 4.62 f | 42.80 ± 2.09 f |
| LvSa35Nc | 46.37 ± 2.33 g | 50.82 ± 0.16 g |
| LvSa40Nc | 58.44 ± 0.30 h | 51.41 ± 2.76 h |
| Lv25Nc | 25.07 ± 2.72 i | 28.98 ± 2.02 i |
| Sa25Nc | 35.23 ± 1.29 j | 46.17 ± 1.85 j |
| 25Nc | 30.98 ± 1.00 | 33.81 ± 2.0 |
| NMP | 9.06 ± 3.69 a | 3.45 ± 0.23 a |
| Formulation | Neonate Porcine Skin | Porcine Buccal Membrane | ||
|---|---|---|---|---|
| Flux (µg/cm2/min) | Lag Time (min) | Flux (µg/cm2/min) | Lag Time (min) | |
| Salicylic acid | ||||
| SaN | 0.0030 ± 0.0017 | 235.29 ± 42.88 | 0.0907 ± 0.0128 | 46.35 ± 6.42 |
| LvSa25Nc | 0.0010 ± 0.0003 | 297.78 ± 15.97 | 0.0322 ± 0.0018 | 39.40 ± 12.47 |
| LvSa40Nc | 0.0003 ± 0.0001 | 335.67 ± 62.10 | 0.0127 ± 0.0001 | 26.81 ± 11.60 |
| Levofloxacin HCl | ||||
| SaN | 0.0178 ± 0.0150 | 95.31 ± 102.41 | 0.0415 ± 0.0546 | 162.01 ± 26.49 |
| LvSa25Nc | 0.0003 ± 0.0001 | 321.34 ± 170.65 | 0.0047 ± 0.0017 | 131.66 ± 93.87 |
| LvSa40Nc | 0.0001 ± 0.0000 | 606.00 ± 57.16 | 0.0009 ± 0.0008 | 1856.00 ± 193.28 |
| (A) | ||||||
| Compartment | SaN | LvSa25Nc | LvSa40Nc | |||
| (µg) | (%) | (µg) | (%) | (µg) | (%) | |
| Donor chamber | 4499.07 ± 1316.10 | 80.38 | 4518.37 ± 442.07 | 67.98 | 6287.37 ± 584.51 | 93.93 |
| Skin membrane | 898.01 ± 53.84 | 16.04 | 2052.83 ± 224.75 | 30.88 | 384.97 ± 91.38 | 5.75 |
| Receptor chamber | 199.83 ± 39.92 | 3.57 | 75.65 ± 12.21 | 1.14 | 21.53 ± 1.74 | 0.32 |
| (B) | ||||||
| Compartment | SaN | LvSa25Nc | LvSa40Nc | |||
| (µg) | (%) | (µg) | (%) | (µg) | (%) | |
| Donor chamber | 2600.58 ± 167.32 | 84.91 | 2811.30 ± 234.81 | 84.60 | 3272.21 ± 271.96 | 97.82 |
| Skin membrane | 345.38 ± 31.68 | 11.31 | 505.75 ± 91.61 | 15.20 | 69.08 ± 0.8983 | 2.07 |
| Receptor chamber | 115.82 ± 94.10 | 3.78 | 6.71 ± 2.58 | 0.20 | 3.98 ± 0.1145 | 0.12 |
| (A) | ||||||
| Compartment | SaN | LvSa25Nc | LvSa40Nc | |||
| (µg) | (%) | (µg) | (%) | (µg) | (%) | |
| Donor chamber | 4171.27 ± 278.80 | 63.15 | 5229.84 ± 323.23 | 81.82 | 5170.67 ± 56.90 | 84.73 |
| Buccal membrane | 500.37 ± 57.34 | 7.58 | 424.71 ± 275.63 | 6.64 | 341.97 ± 153.71 | 5.60 |
| Receptor chamber | 1933.42 ± 18.22 | 29.27 | 736.98 ± 130.23 | 11.53 | 590.19 ± 38.92 | 9.67 |
| (B) | ||||||
| Compartment | SaN | LvSa25Nc | LvSa40Nc | |||
| (µg) | (%) | (µg) | (%) | (µg) | (%) | |
| Donor chamber | 1814.35 ± 190.44 | 60.67 | 2889.29 ± 154.51 | 90.40 | 2958.68 ± 82.50 | 97.01 |
| Buccal membrane | 735.80 ± 93.30 | 24.60 | 201.64 ± 124.58 | 6.31 | 46.11 ± 8.83 | 1.51 |
| Receptor chamber | 440.59 ± 111.67 | 14.73 | 105.15 ± 3.30 | 3.29 | 45.10 ± 23.50 | 1.48 |
| Formula | Inhibition Zone ± S.D. (mm) | |||
|---|---|---|---|---|
| S. aureus ATCC 6538 | E. epidermidis ATCC 5868 | P. acnes ATCC 14,916 | P. gingivalis ATCC 33,277 | |
| LvN | 37.3 ± 1.2 | 45.0 ± 1.7 | 73.1 ± 1.1 | 34.9 ± 0.8 |
| SaN | 18.3 ± 1.5 | 18.3 ± 0.6 | 29.7 ± 0.3 | 19.1 ± 0.2 |
| LvSa10Nc | 34.3 ± 0.6 | 40.0 ± 17 | 66.3 ± 2.0 | 33.7 ± 1.5 |
| LvSa15Nc | 33.0 ± 0.0 | 38.0 ± 1.0 | 64.4 ± 0.9 | 31.7 ± 1.9 |
| LvSa20Nc | 32.7 ± 0.6 | 38.3 ± 0.6 | 63.7 ± 0.6 | 29.0 ± 1.8 |
| LvSa25Nc | 33.3 ± 0.6 e | 39.0 ± 1.0 f | 62.3 ± 2.3 g | 27.8 ± 0.7 h |
| LvSa30Nc | 32.3 ± 0.6 | 39.7 ± 0.6 | 62.3 ± 0.5 | 27.6 ± 0.4 |
| LvSa35Nc | 31.7 ± 0.6 | 38.3 ± 0.6 | 61.7 ± 1.2 | 27.5 ± 0.5 |
| LvSa40Nc | 30.3 ± 0.6 | 38.3 ± 1.2 | 58.6 ± 1.3 | 26.4 ± 0.5 |
| Lv25Nc | 28.3 ± 0.6 e | 34.7 ± 0.6 f | 57.2 ± 0.2 g | 25.0 ± 0.2 h |
| Sa25Nc | 10.7 ± 0.6 | 13.3 ± 0.6 | 20.2 ± 0.5 | 11.9 ± 0.1 |
| 25Nc | 10.8 ± 0.8 a | 10.3 ± 0.6 b | 26.3 ± 0.4 c | 10.3 ± 0.6 d |
| NMP | 16.3 ± 0.6 a | 16.8 ± 1.3 b | 38.2 ± 0.2 c | 18.0 ± 0.0 d |
Disclaimer/Publisher’s Note: The statements, opinions and data contained in all publications are solely those of the individual author(s) and contributor(s) and not of MDPI and/or the editor(s). MDPI and/or the editor(s) disclaim responsibility for any injury to people or property resulting from any ideas, methods, instructions or products referred to in the content. |
© 2024 by the authors. Licensee MDPI, Basel, Switzerland. This article is an open access article distributed under the terms and conditions of the Creative Commons Attribution (CC BY) license (https://creativecommons.org/licenses/by/4.0/).
Share and Cite
Khaing, E.M.; Jitrangsri, K.; Chomto, P.; Phaechamud, T. Nitrocellulose for Prolonged Permeation of Levofloxacin HCl-Salicylic Acid In Situ Gel. Polymers 2024, 16, 989. https://doi.org/10.3390/polym16070989
Khaing EM, Jitrangsri K, Chomto P, Phaechamud T. Nitrocellulose for Prolonged Permeation of Levofloxacin HCl-Salicylic Acid In Situ Gel. Polymers. 2024; 16(7):989. https://doi.org/10.3390/polym16070989
Chicago/Turabian StyleKhaing, Ei Mon, Kritamorn Jitrangsri, Parichart Chomto, and Thawatchai Phaechamud. 2024. "Nitrocellulose for Prolonged Permeation of Levofloxacin HCl-Salicylic Acid In Situ Gel" Polymers 16, no. 7: 989. https://doi.org/10.3390/polym16070989
APA StyleKhaing, E. M., Jitrangsri, K., Chomto, P., & Phaechamud, T. (2024). Nitrocellulose for Prolonged Permeation of Levofloxacin HCl-Salicylic Acid In Situ Gel. Polymers, 16(7), 989. https://doi.org/10.3390/polym16070989

